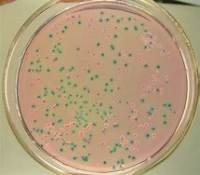
微生物检测

相关产品推荐更多 >
万千商家帮你免费找货
0 人在求购买到急需产品
- 详细信息
- 询价记录
- 技术资料
科研道路荆棘丛生,Cell Mentor 与你同行
你的科研指南:洞察力,建议和技巧
Cell Mentor是Cell出版社和Cell Signaling Technology(CST)联合创建的线上教育资源(www.cellmentor.com),该资源旨在让生物医学学生和研究人员能够更轻松地掌控他们的职业生涯、发表文章并加强他们的实验技能,从而获得实验的成功。
获得启发:从被公认为各个领域带头人的科学家视角,学习他们的失败和成功的经验,了解他们的科研新方向。
技术指导:从CST提供的实验操作流程、技巧和方法的视频中,解决不同技术的难题,让你更可能在第一时间获得实验结果。
发表文献:当你准备发表文章时,这里提供该做什么以及该如何做的一些建议,从Cell Press专业编辑那里学习出版的细节。
就业指导:编辑们在那里等你咨询,无论你是否对从学术界到工业界的转变感兴趣,或想建立自己的实验室,我们的专家都会为你引路。
由国际免疫学联合会和中国免疫学会联合主办的第17届国际免疫学大会(17th International Congress of Immunology, 17th ICI)(IUIS2019)将于2019年10月19-23日在北京国家会议中心召开。10月21日晚,由Cell Mentor主办的特色论坛——纵览免疫前沿,与Cell Mentor同行暨庆祝晚宴将在北京北辰洲际酒店隆重举行。CST和Cell Press诚挚邀请各位研究人员报名参加此次盛宴!欢迎您预报名本次网络直播。

著名的免疫学者曹雪涛教授、田志刚教授、邓宏魁教授将分别进行感染与免疫中天然免疫分子及其调控因子的鉴定、基于NK细胞的肿瘤免疫疗法、干细胞研究及应用进展的主旨演讲。此外,CST亚太/中国总经理董增军先生将介绍Cell Mentor的起源以及它将如何促进科学实验的成功。同样令人十分期待的是,Cell Press旗下 Immunity 杂志的主编Peter Lee将详细介绍免疫学前沿及如何在 Cell、Immunity 等杂志中发表论文。随后的圆桌讨论环节,大咖们将对当今免疫学前沿、以及如何在 Cell 发表文章,那些 Cell 级的灵感从何而来,发表 Cell 后的人生等话题进行激烈讨论。期待自己也能发 Cell 的朋友们,千万不要错过哦!
| 时间 | 主题 | 嘉宾 |
|---|---|---|
| 18:30-18:35 | Introduction of Agenda and Cell Mentor | Jay Dong/董增军 |
| 18:35-18:50 | Identification of Innate Molecules and Their Regulators in Infection and Immunity | Xuetao Cao/曹雪涛 |
| 18:50-19:05 | NK Cell-Based Lmmunotherapy of Cancer | Zhigang Tian/田志刚 |
| 19:05-19:20 | What's Trending in the Field of Lmmunology and in the World of Publishing | Peter Lee |
| 19:20-19:35 | Advances in Stem Cell Research and Applications | Hongkui Deng/邓宏魁 |
| 19:35-19:45 | Cell Mentor Launching Ceremony | -- |
| 19:45-20:15 | Cell or Life?And the "Life"of Publishing in Cell | New Frontiers Panel Discussion |
| 20:15-20:20 | Conclusion Speech&Cell Mentor Introduction Video | Conclusion Speech |
直播时间:10月21日18:30-20:30
赶快抓住这次机会,和现场观众一起聆听免疫大咖和资深主编的精彩演讲。点我报名!
风险提示:丁香通仅作为第三方平台,为商家信息发布提供平台空间。用户咨询产品时请注意保护个人信息及财产安全,合理判断,谨慎选购商品,商家和用户对交易行为负责。对于医疗器械类产品,请先查证核实企业经营资质和医疗器械产品注册证情况。
- 作者
- 内容
- 询问日期
技术资料暂无技术资料 索取技术资料